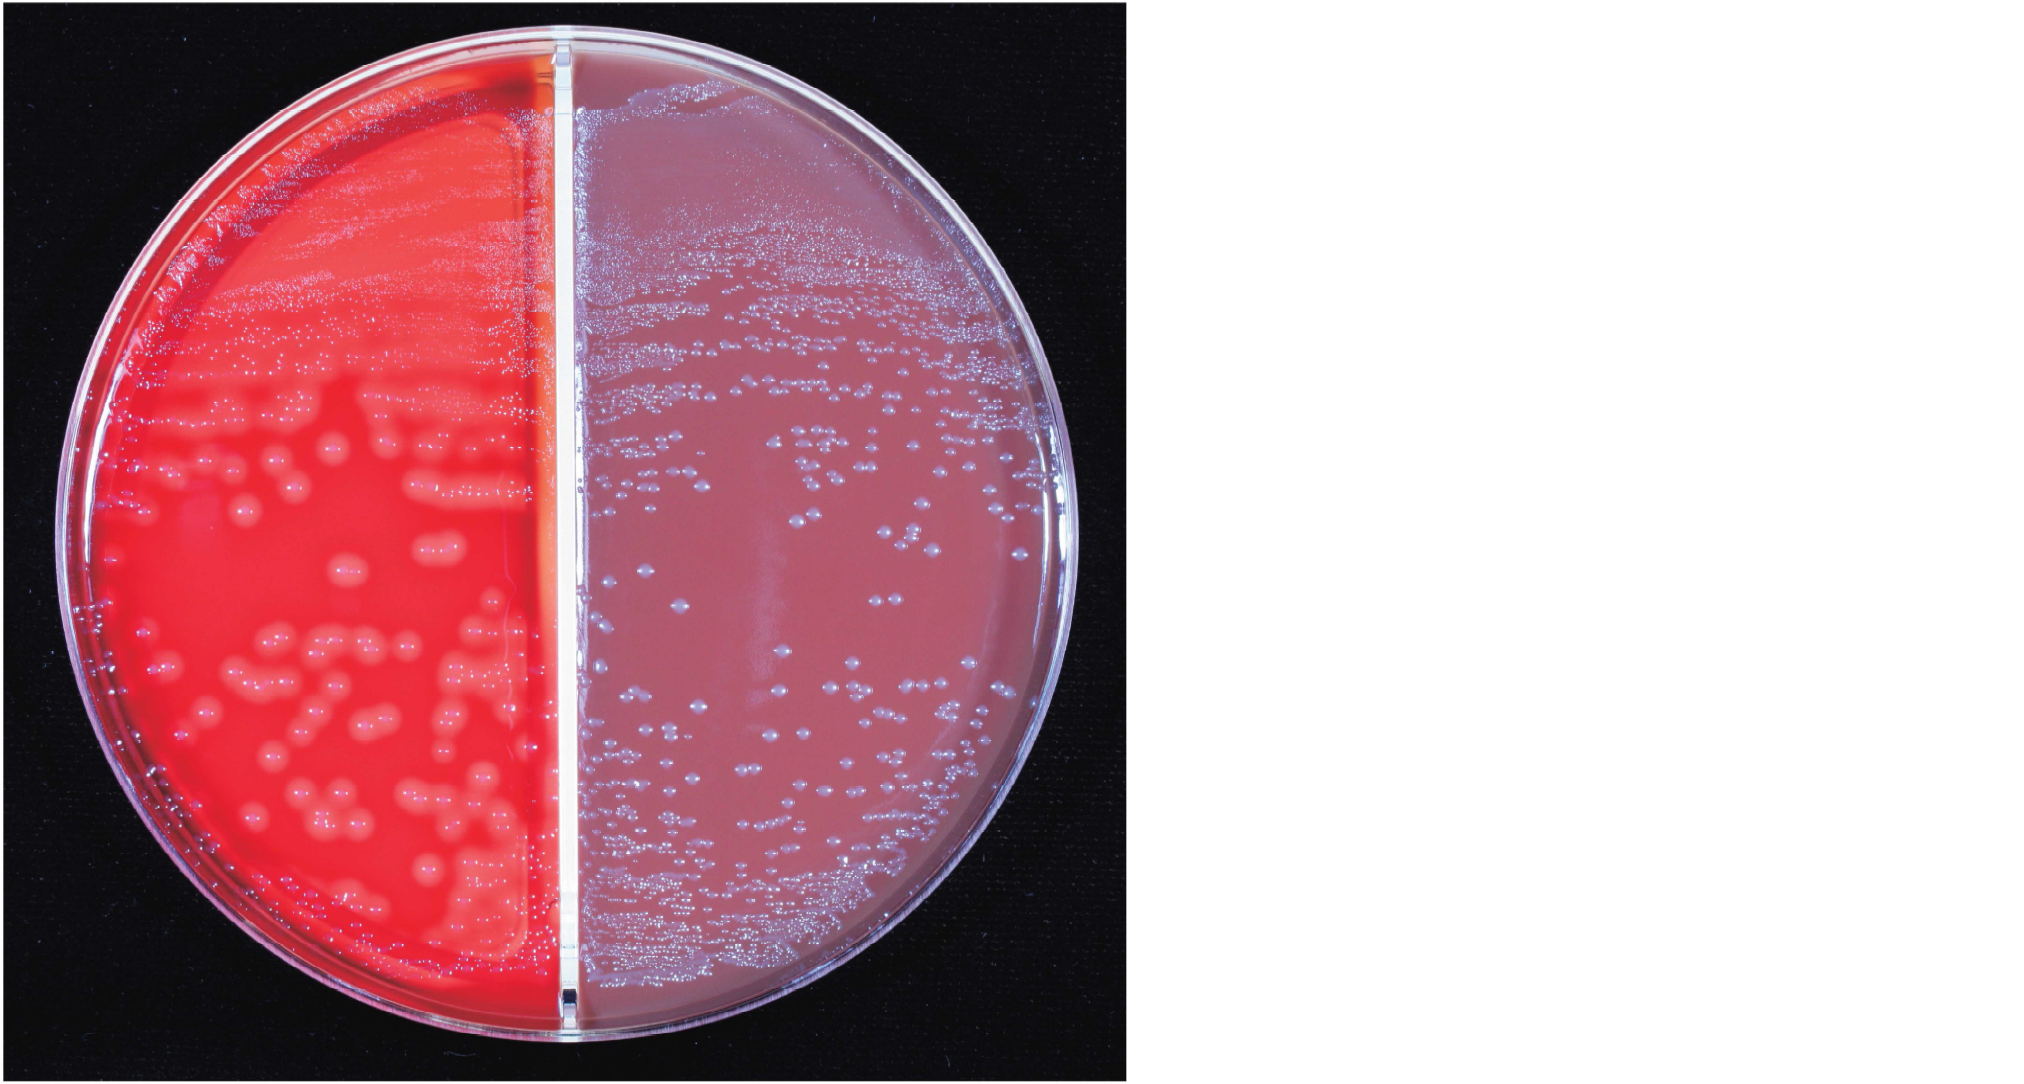

急性咽頭炎患者の咽頭粘液を5%ヒツジ血液寒天培地(左)とチョコレート寒天培地(右)の分画培地に接種し,35℃で24時間炭酸ガス培養を行った培地を示す。分離菌は,グラム陽性球菌,カタラーゼテスト陰性,LancefieldのA群抗原陽性であった。
推定される菌種はどれか。
- 1. Streptococcus agalactiae
- 2. Streptococcus mitis
- 3. Streptococcus pneumoniae
- 4. Streptococcus pyogenes
- 5. Streptococcus sanguinis